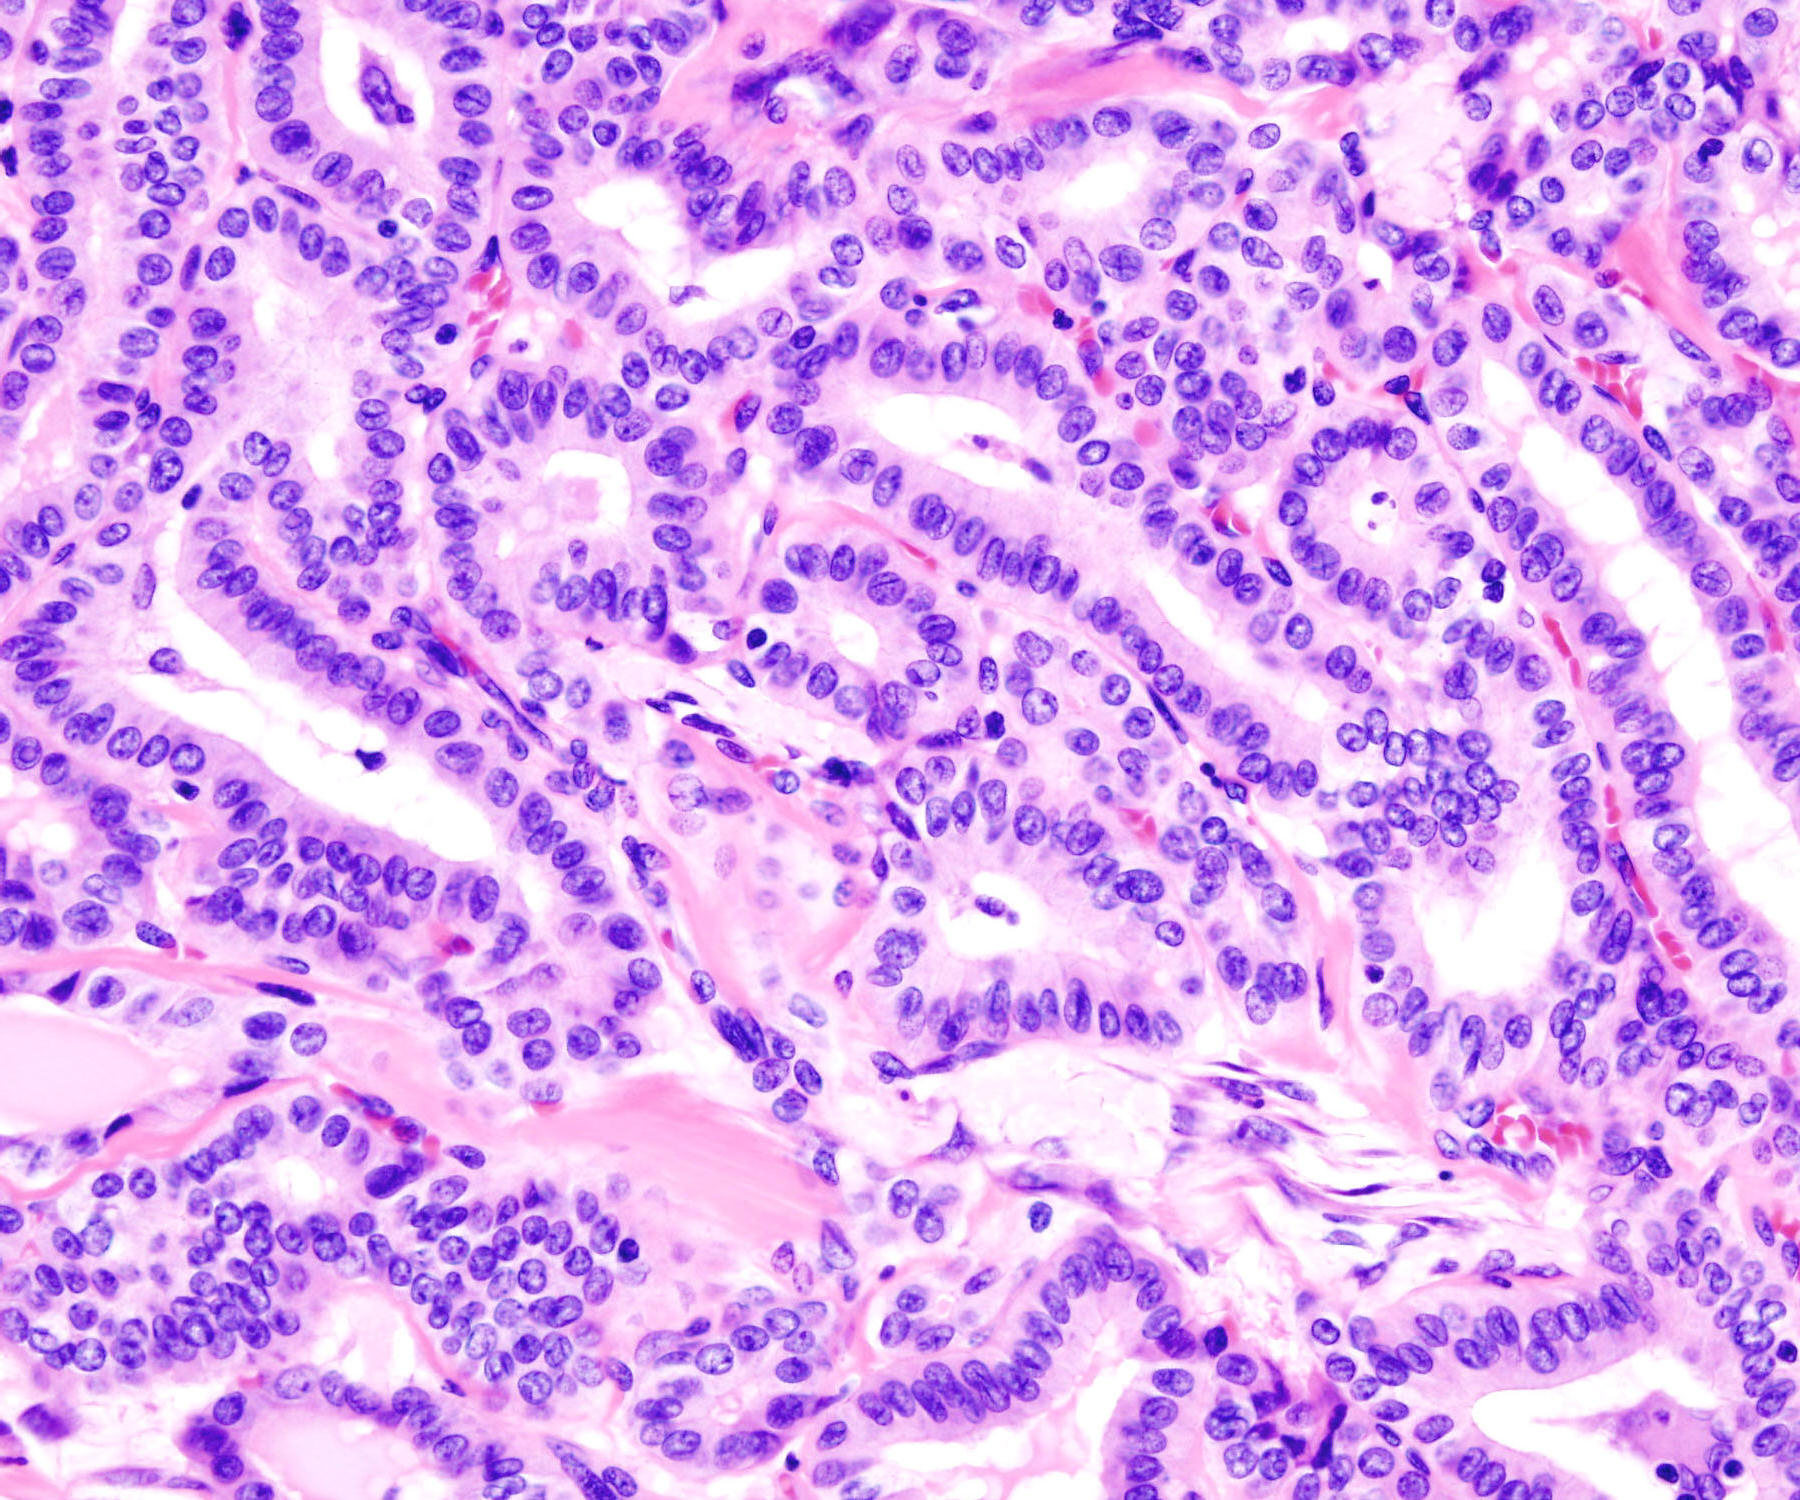

Date: 8 January 2006
Author: KGH
Licence: GNU Free Documentation License
|
|
|
|---|---|
|
|
|
|
Source: Thyroid_papillary_carcinoma_histopatholgy_(2)
Date: 8 January 2006 Author: KGH Licence: GNU Free Documentation License |
© oktober 2007 marius loots